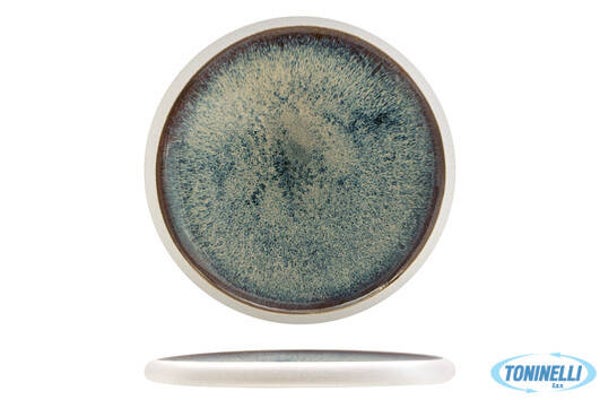
NEW GENESYS BLU-PIATTO BASSO CM.23 IN PORCELLANA CB3543-23-F929 Art. 18021   EAN 8010415239249

NEW GENESYS BLU-PIATTO BASSO CM.23 IN PORCELLANA CB3543-23-F929 Art. 18021 EAN 8010415239249
10,09 €
Codice articolo:
18021
PRESTIGIOSA LINEA DI PIATTI IN PORCELLANA. LE FORME IRREGOLARI RAPPRESENTANO UN OMAGGIO ALLA TERRA EDN ALLA NATURA, E GARANTISCONO UNA MISE EN TABLE ORIGINALE E MAI BANALE